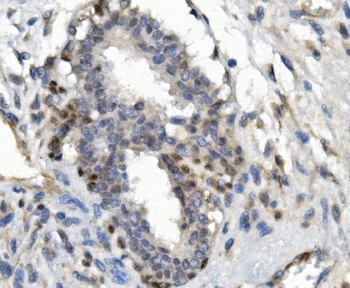
FOXP1 Rabbit Polyclonal Antibody

You have no items in your shopping cart.
All Products
- Filamin A/FLNA Mouse Monoclonal Antibody [orb692222]
IF, IHC, WB
Human
Mouse
Monoclonal
Unconjugated
100 μg FC, ICC, IF, IHC, WB
Human, Mouse, Rat
Mouse
Monoclonal
Unconjugated
100 μg- ASS1 Mouse Monoclonal Antibody [orb692228]
FC, ICC, IF, IHC, WB
Human, Monkey, Mouse, Rat
Mouse
Monoclonal
Unconjugated
100 μg - ASS1 Mouse Monoclonal Antibody [orb692229]
FC, ICC, IF, IHC, WB
Human, Monkey, Mouse, Rat
Mouse
Monoclonal
Unconjugated
100 μg - Transketolase/TKT Mouse Monoclonal Antibody [orb738409]
FC, ICC, IF, IHC, WB
Human, Mouse, Rat
Mouse
Monoclonal
Unconjugated
100 μg - PI-16/PI16/PI Rabbit Polyclonal Antibody [orb670319]
ELISA, FC, IHC, WB
Human, Monkey, Mouse, Rat
Rabbit
Polyclonal
Unconjugated
100 μg - FOXP1 Rabbit Polyclonal Antibody [orb669176]
IHC, WB
Human, Monkey, Mouse, Rat
Rabbit
Polyclonal
Unconjugated
100 μg - Astrin/Deepest/SPAG5 Rabbit Polyclonal Antibody [orb745970]
ELISA, FC, ICC, IF, IHC, WB
Human
Rabbit
Polyclonal
Unconjugated
100 μg - Gephyrin/GPHN Rabbit Polyclonal Antibody [orb763172]
ELISA, ICC, IF, IHC, WB
Human, Monkey, Mouse, Rat
Rabbit
Polyclonal
Unconjugated
100 μg ELISA, FC, ICC, IF, IHC, WB
Human, Mouse, Rat
Rabbit
Polyclonal
Unconjugated
100 μg